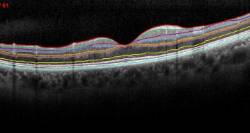
Meeting-del-European-Glaucoma-Panel-en-Londres---Diciembre-2014

Centro Médico Teknon
Centro Médico Teknon- Centro Médico Teknon
 Centro Médico Teknon
Centro Médico Teknon Centro Médico Teknon
Centro Médico Teknon Centro Médico Teknon
Centro Médico Teknon
Medios de comunicación
- Alerta ante las líneas rectas que se ven rotas, El Periódico (03/12/2014)
- Ofensiva contra la ceguera, La Vanguardia (06/10/2014)
- Ojos con protección solar, La Vanguardia (27/07/2014)
- Ensayo de nueva terapia para la DMAE húmeda, Diario Médico (20/02/2013)
- Redistribuir las dosis reduce el riesgo de rotura del epitelio en degeneración macular, Diario Médico (10/07/2013)
- "Estamos experimentando un avance espectacular en la lucha contra determinadas cegueras", Expansión (28/09/2012)
- Mejora el tratamiento de una causa común de ceguera, La Vanguardia (06/08/2012)
- La BMF impulsa SilVer, una plataforma pionera en tecnologías de asistencia que ayuda a personas ciegas o con baja visión - Abril 2018
 En la sociedad actual, las nuevas tecnologías se hacen cada vez más imprescindibles. El desarrollo tecnológico contribuye a avanzar en la integración tanto digital como social de las personas ciegas o con baja visión. Gracias a las aplicaciones móviles y a los dispositivos de apoyo, se favorece su adaptación al entorno y a sus tareas cotidianas, proporcionando mayor autonomía personal. Pero no todo sirve por igual. Cada persona, en función de su situación, edad y características de su enfermedad, tiene unas necesidades diferentes.
En la sociedad actual, las nuevas tecnologías se hacen cada vez más imprescindibles. El desarrollo tecnológico contribuye a avanzar en la integración tanto digital como social de las personas ciegas o con baja visión. Gracias a las aplicaciones móviles y a los dispositivos de apoyo, se favorece su adaptación al entorno y a sus tareas cotidianas, proporcionando mayor autonomía personal. Pero no todo sirve por igual. Cada persona, en función de su situación, edad y características de su enfermedad, tiene unas necesidades diferentes. De esta reflexión surge el proyecto SilVer (Smart Aids for Visually Impaired) que une los caminos de la Barcelona Macula Foundation (BMF) y de la consultora en accesibilidad digital DRJ.
SilVer es una propuesta pionera. Es una web de consulta gratuita en la que se ha realizado una importante labor de catalogación y selección de apps y dispositivos valorando parámetros como la funcionalidad, la facilidad de uso, el usuario al que va dirigido y el precio, entre otros muchos aspectos. La web incluye 40 propuestas TOP después de haber evaluado exhaustivamente más de 150 herramientas tecnológicas de las que actualmente ofrece el mercado en lo que se denomina "tecnologías de asistencia".
El impulsor de la iniciativa es el Dr. Jordi Monés, fundador de la BMF, especialista en Retina, Mácula y Vítreo e investigador. Monés es un profesional de prestigio internacional sensibilizado ante las dificultades a las que se enfrentan a diario las personas con problemas de baja visión. De su experiencia y conocimientos nace la necesidad de valorar los dispositivos teniendo en cuenta no sólo la patología de las personas — que pueden tener pérdida de visión central o periférica, siendo diferentes sus necesidades — sino también su edad y características personales. Las personas mayores, que por ejemplo sufren degeneración macular en un momento concreto de su vida, suelen tener dificultad para aprender Braille por lo que necesitan recurrir a otro tipo de dispositivos, con soporte de voz o sonido, que les permitan adaptarse a la nueva situación.
En la parte técnica del proyecto y al frente de la consultora DRJ (conocida también como Macneticos por el nombre del podcast que realizan) se encuentran dos personas ciegas especializadas en accesibilidad digital. Daniela Rubio y José Vicente González forman un tándem de éxito; ella como consultora en accesibilidad digital y certificada como Apple Distinguished Educator y él como experto en marketing digital. Sus diferentes experiencias vitales con la ceguera, así como las vivencias de otros miembros de su equipo, les han permitido analizar estos dispositivos desde una doble perspectiva, la profesional y la personal, por lo que sus opiniones tienen un valor añadido.
- Dr. Jordi Monés: «En 10 años dispondremos de terapias eficaces para luchar contra la DMAE atrófica» - Marzo 2016
 La DMAE atrófica no tiene tratamiento hoy en día, al contrario que la forma húmeda de la enfermedad, para la cual existen tratamientos específicos que pueden controlar su proceso. El Dr. Jordi Monés explicó en el programa Bentrobats (La Xarxa TV) que en los primeros años del siglo XXI «hemos domesticado la DMAE húmeda, y en los próximos 10 años lo haremos con la atrófica. Es un hito muy importante». El Dr. Monés prevé que «en los próximos 10 años» contaremos con «terapias eficaces, tanto para la variante atrófica de la DMAE como para la enfermedad de Stargardt». Recupera la entrevista en el enlace
La DMAE atrófica no tiene tratamiento hoy en día, al contrario que la forma húmeda de la enfermedad, para la cual existen tratamientos específicos que pueden controlar su proceso. El Dr. Jordi Monés explicó en el programa Bentrobats (La Xarxa TV) que en los primeros años del siglo XXI «hemos domesticado la DMAE húmeda, y en los próximos 10 años lo haremos con la atrófica. Es un hito muy importante». El Dr. Monés prevé que «en los próximos 10 años» contaremos con «terapias eficaces, tanto para la variante atrófica de la DMAE como para la enfermedad de Stargardt». Recupera la entrevista en el enlace .
. - La Dra. Pazos obtiene el Cum Laude en la defensa de su tesis doctoral - Febrero 2016
 La Dra. Marta Pazos superó con la calificación máxima la defensa de la tesis doctoral Anatomía del nervio óptico en la rata en reconstrucciones histomorfométricas en 3D de ojos normales y con glaucoma precoz experimental, un trabajo con proyección internacional que aporta nuevos puntos de referencia para detectar el desarrollo de la neuropatía glaucomatosa experimental en ojos de rata. En esta investigación, la Dra. Pazos plantea una reconstrucción en 3D del nervio óptico de rata con glaucoma experimental precoz para proporcionar la primera descripción anatómica tridimensional de los ojos normales y del glaucoma precoz experimental en esta especie. Este es el modelo de glaucoma animal más extendido en el mundo.
La Dra. Marta Pazos superó con la calificación máxima la defensa de la tesis doctoral Anatomía del nervio óptico en la rata en reconstrucciones histomorfométricas en 3D de ojos normales y con glaucoma precoz experimental, un trabajo con proyección internacional que aporta nuevos puntos de referencia para detectar el desarrollo de la neuropatía glaucomatosa experimental en ojos de rata. En esta investigación, la Dra. Pazos plantea una reconstrucción en 3D del nervio óptico de rata con glaucoma experimental precoz para proporcionar la primera descripción anatómica tridimensional de los ojos normales y del glaucoma precoz experimental en esta especie. Este es el modelo de glaucoma animal más extendido en el mundo. - "El camino para controlar enfermedades como la DMAE o Stargardt está trazado, pero se necesitan muchos recursos para hacer investigación" - Enero 2016
El Dr. Jordi Monés defiende, en el suplemento "A tu salud" del diario La Razón, la necesidad de más financiación para los proyectos de investigación alrededor de enfermedades como la Degeneración Macular Asociada a la Edad (DMAE), la Retinosis Pigmentaria o la enfermedad de Stargardt. El Doctor Monés también asegura que con la inversión adecuada se podrían tener terapias eficaces basadas en la utilización de células madre en «5 o 10 años».
«El camino está trazado, pero se necesitan muchos recursos para hacer investigación y muchas veces éste es el paso limitante, que no tenemos músculo suficiente para poder arrancar proyectos de envergadura teniendo a disposición mucho talento científico». Por lo que respecta a la DMAE, el Dr. Monés apunta que «en la forma húmeda podemos frenar y, en algunos casos, recuperar visión, pero entonces hay que coger la enfermedad justo cuando empieza. En cualquier casos, pararla ya es mucho en una enfermedad tan destructiva». - En el XXV Congreso SEPCOO el Dr. Nieto presenta "Cirugía de la ptosis palpebral" - Junio 2015
 El Dr. José Nieto, oftalmólogo especialista en cirugía plástica ocular del Institut de la Màcula ha ofrecido una presentación sobre "Cirugía de la ptosis aponeurótica" en el VII Curso de Formación de la Sociedad Española de Cirugía Plástica Ocular y Orbitaria en el XXV Congreso de la Sociedad realizado en Salamanca el 17, 18 y 19 de junio.La ptosis palpebral es la caída de uno o los dos párpados de forma que cubren el iris más de lo normal. Esto ocasiona una pérdida de campo visual, fatiga visual y una alteración estética en forma de mirada triste o cansada. Existen varios tipos de parpados caídos, aunque el más frecuente es el párpado caído senil, que aparece con la edad. Además, la ptosis palpebral también puede ser congénita o estar relacionada con enfermedades musculares.El tratamiento de la ptosis palpebral es quirúrgico, y la técnica escogida depende del caso. La tendencia actual es ir hacia cirugías mínimamente invasivas con recuperación muy rápida.En la sesión el Dr. Nieto ha repasado las técnicas que se llevan a cabo en este tipo de cirugías y la evolución de las mismas.
El Dr. José Nieto, oftalmólogo especialista en cirugía plástica ocular del Institut de la Màcula ha ofrecido una presentación sobre "Cirugía de la ptosis aponeurótica" en el VII Curso de Formación de la Sociedad Española de Cirugía Plástica Ocular y Orbitaria en el XXV Congreso de la Sociedad realizado en Salamanca el 17, 18 y 19 de junio.La ptosis palpebral es la caída de uno o los dos párpados de forma que cubren el iris más de lo normal. Esto ocasiona una pérdida de campo visual, fatiga visual y una alteración estética en forma de mirada triste o cansada. Existen varios tipos de parpados caídos, aunque el más frecuente es el párpado caído senil, que aparece con la edad. Además, la ptosis palpebral también puede ser congénita o estar relacionada con enfermedades musculares.El tratamiento de la ptosis palpebral es quirúrgico, y la técnica escogida depende del caso. La tendencia actual es ir hacia cirugías mínimamente invasivas con recuperación muy rápida.En la sesión el Dr. Nieto ha repasado las técnicas que se llevan a cabo en este tipo de cirugías y la evolución de las mismas. - Cuida tus ojos de las alergias, sobre todo en primavera - Mayo 2015
 La prevalencia de las enfermedades alérgicas asciende en todo el mundo, tanto en los países occidentales como en los países en desarrollo, éstas, en muchos casos afectan a nuestros ojos.Se calcula que alrededor del 35% de la población mundial sufre una o más enfermedades alérgicas. La más común, la alergia al polen o polinosis, que afecta al 15% de la población y hasta un 30% de jóvenes.El polen es el causante de la alergia ocular primaveral. Además del polen, esta alergia está causada generalmente por alérgenos que se transmiten por el aire como hongos, ácaros y pelos de animales domésticos. Los síntomas de estas alergias son picor o escozor, lagrimeo, enrojecimiento ocular e inflamación de los párpados. Los síntomas suelen aparecer en ambos ojos.La Dra. Paula Verdaguer, oftalmóloga especialista en córnea, cirugía refractiva y catarata del Institut de la Màcula, recomienda "visitar al oftalmólogo una vez detectados los primeros síntomas de alergia". Para la Dra., estas visitas son "indispensables para administrar el tratamiento correcto y para explicar las medidas de prevención de posibles nuevos episodios".La medida de prevención más eficaz es el control ambiental, evitando la exposición al alérgeno causante, aunque en muchos casos no siempre es posible. Se pueden realizar pruebas de alergia para determinar los alérgenos causantes y valorar el posible tratamiento mediante vacunas. Cuando la exposición ya se ha producido es importante lavar bien los ojos para limpiar los alérgenos de la superficie ocular.Para el tratamiento de las conjuntivitis alérgicas leves se utilizan antihistamínicos tópicos que generalmente resuelven el episodio. En casos de alergia ocular más severos, añadimos corticoides tópicos. Los corticoides pueden tener efectos secundarios a nivel ocular, con lo que el uso y control de este medicamento tiene que ser prescrito siempre por un oftalmólogo.
La prevalencia de las enfermedades alérgicas asciende en todo el mundo, tanto en los países occidentales como en los países en desarrollo, éstas, en muchos casos afectan a nuestros ojos.Se calcula que alrededor del 35% de la población mundial sufre una o más enfermedades alérgicas. La más común, la alergia al polen o polinosis, que afecta al 15% de la población y hasta un 30% de jóvenes.El polen es el causante de la alergia ocular primaveral. Además del polen, esta alergia está causada generalmente por alérgenos que se transmiten por el aire como hongos, ácaros y pelos de animales domésticos. Los síntomas de estas alergias son picor o escozor, lagrimeo, enrojecimiento ocular e inflamación de los párpados. Los síntomas suelen aparecer en ambos ojos.La Dra. Paula Verdaguer, oftalmóloga especialista en córnea, cirugía refractiva y catarata del Institut de la Màcula, recomienda "visitar al oftalmólogo una vez detectados los primeros síntomas de alergia". Para la Dra., estas visitas son "indispensables para administrar el tratamiento correcto y para explicar las medidas de prevención de posibles nuevos episodios".La medida de prevención más eficaz es el control ambiental, evitando la exposición al alérgeno causante, aunque en muchos casos no siempre es posible. Se pueden realizar pruebas de alergia para determinar los alérgenos causantes y valorar el posible tratamiento mediante vacunas. Cuando la exposición ya se ha producido es importante lavar bien los ojos para limpiar los alérgenos de la superficie ocular.Para el tratamiento de las conjuntivitis alérgicas leves se utilizan antihistamínicos tópicos que generalmente resuelven el episodio. En casos de alergia ocular más severos, añadimos corticoides tópicos. Los corticoides pueden tener efectos secundarios a nivel ocular, con lo que el uso y control de este medicamento tiene que ser prescrito siempre por un oftalmólogo. - La Dra. Marta Pazos expone las últimas novedades de la OCT en el glaucoma - Abril 2015
 La Dra. Marta Pazos, oftalmóloga especializada en Glaucoma del Institut de la Màcula participó en dos cursos sobre el glaucoma realizados en Barcelona y Madrid durante el mes de abril.Primero, el día 9 de abril participó en el XXIII Fórum de Glaucoma Siglo XXI, organizado por Santen que se lleva a cabo en Barcelona. Se trata de un foro exclusivo para especialistas en glaucoma dónde se debaten los principales avances de esta patología. En la presentación "Más allá de la papila: Utilidad de la segmentación macular con el SD-OCT en el glaucoma" la Dra. Pazos expuso un nuevo software de segmentación de las distintas capas de la retina en la mácula, que va a ayudar al diagnóstico de pacientes con glaucoma. Clásicamente la OCT (Tomografía Óptica Coherente) en el glaucoma se ha centrado en el nervio óptico. Sin embargo, cada vez más, la mácula está tomando un papel relevante en el diagnóstico y seguimiento de la enfermedad.El día 10 de abril también participó en un curso de OCT organizado por Heidelberg, donde impartió una charla sobre "La Importancia de la OCT en el glaucoma". Se trata de un curso monográfico sobre la OCT Spectralis, dónde la Dra. explicó cómo sacar el máximo provecho para los pacientes con glaucoma, especialmente a la hora de analizar el nervio óptico, la evaluación de las fibras peripapilares, el examen macular y la detección de la progresión de la patología.
La Dra. Marta Pazos, oftalmóloga especializada en Glaucoma del Institut de la Màcula participó en dos cursos sobre el glaucoma realizados en Barcelona y Madrid durante el mes de abril.Primero, el día 9 de abril participó en el XXIII Fórum de Glaucoma Siglo XXI, organizado por Santen que se lleva a cabo en Barcelona. Se trata de un foro exclusivo para especialistas en glaucoma dónde se debaten los principales avances de esta patología. En la presentación "Más allá de la papila: Utilidad de la segmentación macular con el SD-OCT en el glaucoma" la Dra. Pazos expuso un nuevo software de segmentación de las distintas capas de la retina en la mácula, que va a ayudar al diagnóstico de pacientes con glaucoma. Clásicamente la OCT (Tomografía Óptica Coherente) en el glaucoma se ha centrado en el nervio óptico. Sin embargo, cada vez más, la mácula está tomando un papel relevante en el diagnóstico y seguimiento de la enfermedad.El día 10 de abril también participó en un curso de OCT organizado por Heidelberg, donde impartió una charla sobre "La Importancia de la OCT en el glaucoma". Se trata de un curso monográfico sobre la OCT Spectralis, dónde la Dra. explicó cómo sacar el máximo provecho para los pacientes con glaucoma, especialmente a la hora de analizar el nervio óptico, la evaluación de las fibras peripapilares, el examen macular y la detección de la progresión de la patología. - Dos oftalmólogos especialistas en retina se incorporan al Institut de la Màcula - Abril 2015
 El Institut de la Màcula, para seguir ofreciendo los mejores especialistas a sus pacientes, ha incorporado a la Dra. Anna Sala y al Dr. Francesc March de Ribot, especialistas en retina y segmento posterior y retina respectivamente.La Dra. Anna Sala es Licenciada en Medicina y Cirugía por la Universitat de Barcelona, y se especializó en Oftalmología en el Hospital Universitario de Valladolid, dónde también cursó un Máster en Investigación en Ciencias de la Visión y un Máster Oficial en Retina.También adquirió un fellowship clínico y de investigación en Retina Médica en el Manchester Royal Eye Hospital, donde participó en distintos ensayos clínicos y proyectos de investigación. Por último, realizó un fellowship quirúrgico en Vítreo-Retina en el Royal Liverpool Hospital. La doctora es especialista en el diagnóstico y tratamiento de patologías de la retina, así como en su tratamiento médico y quirúrgico. En los últimos años ha participado en diversas publicaciones en revistas internacionales y congresos nacionales e internacionales. Además, es miembro de la Association for Research in Vision and Ophthalmology (ARVO) y de la Sociedad Española de Retina y Vítreo (SERV).El Dr. Francesc March de Ribot es Licenciado en Medicina y Cirugía por la Universitat de Lleida. Se especializó en Oftalmología en el Hospital Universitari Parc Taulí de Sabadell. Posteriormente consiguió un fellowship clínico, quirúrgico y de investigación en Retina Médica y Quirúrgica y uno de Catarata y Microcirugía del segmento anterior. Además, ha participado en distintos ensayos clínicos y proyectos de investigación utilizando técnicas de última generación en retina y segmento anterior.El Dr. March de Ribot es especialista en el diagnóstico y tratamiento de las patologías retinianas y del segmento anterior, así como en su tratamiento médico y quirúrgico. En los últimos años ha llevado a cabo diversas publicaciones en revistas internacionales y ha participado en congresos nacionales e internacionales. A su vez, es miembro de la European Society of Retina Specialists (EURETINA) y de la Sociedad Española de Retina y Vítreo (SERV).
El Institut de la Màcula, para seguir ofreciendo los mejores especialistas a sus pacientes, ha incorporado a la Dra. Anna Sala y al Dr. Francesc March de Ribot, especialistas en retina y segmento posterior y retina respectivamente.La Dra. Anna Sala es Licenciada en Medicina y Cirugía por la Universitat de Barcelona, y se especializó en Oftalmología en el Hospital Universitario de Valladolid, dónde también cursó un Máster en Investigación en Ciencias de la Visión y un Máster Oficial en Retina.También adquirió un fellowship clínico y de investigación en Retina Médica en el Manchester Royal Eye Hospital, donde participó en distintos ensayos clínicos y proyectos de investigación. Por último, realizó un fellowship quirúrgico en Vítreo-Retina en el Royal Liverpool Hospital. La doctora es especialista en el diagnóstico y tratamiento de patologías de la retina, así como en su tratamiento médico y quirúrgico. En los últimos años ha participado en diversas publicaciones en revistas internacionales y congresos nacionales e internacionales. Además, es miembro de la Association for Research in Vision and Ophthalmology (ARVO) y de la Sociedad Española de Retina y Vítreo (SERV).El Dr. Francesc March de Ribot es Licenciado en Medicina y Cirugía por la Universitat de Lleida. Se especializó en Oftalmología en el Hospital Universitari Parc Taulí de Sabadell. Posteriormente consiguió un fellowship clínico, quirúrgico y de investigación en Retina Médica y Quirúrgica y uno de Catarata y Microcirugía del segmento anterior. Además, ha participado en distintos ensayos clínicos y proyectos de investigación utilizando técnicas de última generación en retina y segmento anterior.El Dr. March de Ribot es especialista en el diagnóstico y tratamiento de las patologías retinianas y del segmento anterior, así como en su tratamiento médico y quirúrgico. En los últimos años ha llevado a cabo diversas publicaciones en revistas internacionales y ha participado en congresos nacionales e internacionales. A su vez, es miembro de la European Society of Retina Specialists (EURETINA) y de la Sociedad Española de Retina y Vítreo (SERV). - El Institut de la Màcula i de la Retina, primer centro europeo en realizar el ensayo Chroma - Febrero 2015
El ensayo, en fase III, tiene por objetivo comprobar la seguridad y eficacia de un medicamento que podría frenar la progresión de la Atrofia Geográfica (AG)
Evaluar la eficacia y seguridad del medicamento Lampalizumab en pacientes con Atrofia Geográfica (AD), una forma de Degeneración Macular Asociada a la Edad (DMAE) grave. Este es el objetivo principal de un nuevo ensayo clínico, que se encuentra en fase de reclutamiento, y que se realizará en el Institut de la Màcula i de la Retina, situado en Hospital Quirón Teknon. El Institut de la Màcula es el primer centro europeo acreditado para poder trabajar en este ensayo.
Las primeras fases del estudio del Lampalizumab han demostrado eficacia en la detención de la progresión de la enfermedad. Ahora, los ensayos de fase III (Chroma y Spectri) pretenden analizar resultados a uno y dos años para demostrar la eficacia (las primeras fases mostraron una reducción del 20% en la progresión de la enfermedad en año y medio) y el impacto del tratamiento sobre la función visual de los pacientes con la aplicación de inyecciones intravítreas del medicamento experimental. Para realizar estos estudios se reclutaran alrededor de 1.000 pacientes de unos 300 centros de investigación en 24 países. "Mientras que la fase II del ensayo mostró resultados en la reducción del progreso de la enfermedad, se espera que la fase III muestre mejoras en la degeneración", afirma el Dr. Jordi Monés, oftalmólogo de Hospital Quirón Teknon.
La Atrofia Geográfica (AG) afecta a más de cinco millones de personas en el mundo y puede provocar ceguera. El medicamento experimental está compuesto por un fragmento de unión a antígeno (fab) de un anticuerpo monoclonal humanizado dirigido contra el factor del complemento D.
- La Dra. Marta Pazos recibió un diploma de reconocimiento en el Meeting del European Glaucoma Panel en Londres - Diciembre 2014
Imagen en alta resolución. Este enlace se abrirá mediante lightbox, puede haber un cambio de contextoLa Dra. Marta Pazos, oftalmóloga especializada en glaucoma del Institut de la Màcula i de la Retina recibió un reconocimiento en el Meeting del European Glaucoma Panel que se celebró entre los días 11 y 14 de diciembre en la ciudad de Londres.
Imagen en alta resolución. Este enlace se abrirá mediante lightbox, puede haber un cambio de contextoLa Dra. Marta Pazos, oftalmóloga especializada en glaucoma del Institut de la Màcula i de la Retina recibió un reconocimiento en el Meeting del European Glaucoma Panel que se celebró entre los días 11 y 14 de diciembre en la ciudad de Londres.Este encuentro es la última reunión de la beca para jóvenes investigadores en glaucoma que incluye un programa de monitorización y educación por parte del Dr. David Garway-Heath y cuyo patrocinio corre a cargo de los laboratorios Allergan.
Durante el Meeting se discutieron los artículos de actualidad y se realizó una visita al hospital monográfico Oftalmológico Moorfields de Londres. Allí los asistentes asistieron a las distintas ponencias sobre proyectos innovadores en investigación impartida por profesionales del Daily Telegraph.
Además, se llevó a cabo una ceremonia de graduación dónde se entregó un diploma a los participantes, entre los cuales estaba la Dra. Marta Pazos, por haber completado un programa de 3 años de duración.
El European Glaucoma Panel es un grupo internacional formado por oftalmólogos jóvenes dedicados sobre todo a la investigación y a la mejora de las herramientas y las técnicas en el tratamiento y la investigación del glaucoma.
La revista Investigative Ophthalmology and Visual Science publica un artículo de los Dres. Jordi Monés y Marc Biarnés
La publicación científica Investigative Ophthalmology and Visual Science (IOVS) ha publicado un artículo de los Dres. Jordi Monés, MD, PhD y Marc Biarnés, MPH, PhD, del Institut de la Màcula i de la Retina, juntamente con los doctores Carlos G. Forero, Luís Arias y Jordi Alonso.
El artículo titulado Reappraisal of geographic atrophy patterns seen on fundus autofluorescence using a latent class analysis approach tiene como principal objetivo re-evaluar los patrones de la autofluorescencia (AF) en pacientes con atrofia geográfica (AG) y valorar su estabilidad en el tiempo objetivamente, mediante el análisis de clases latentes (ACL).
La AF es una técnica de imagen que se ha utilizado en los últimos años para clasificar a los pacientes con AG en distintos patrones (fenotipos), distintos grupos definidos a partir de la distribución de AF alrededor de las zonas de atrofia. La importancia de esta caracterización recae en el hecho que estos patrones (10 tipos) están relacionados a la progresión de la enfermedad, de modo que tienen un valor pronóstico de alta importancia. Pese a todo, la clasificación de estos patrones es compleja y se desarrolló inicialmente de manera subjetiva.
El ACL es un método estadístico que relaciona una serie de variables observadas a un conjunto de características no observadas o latentes. Tiene como objetivo detectar la presencia de categorías o clases subyacentes a partir de los patrones de asociación que se indican por parte de los observadores.
A través del análisis de los datos obtenidos se encontró el número óptimo de patrones (clases latentes), que fue de 5. Sorprendentemente, las clases mostraron una correlación positiva con el área de atrofia.
Estos resultados implican que los patrones de autofluorescencia (AF) en Atrofia Geográfica (AG) no son realmente fenotipos (características intrínsecas de los pacientes), sino distintos estadios en la enfermedad. Es decir, que los patrones de AF manifiestan un momento de la enfermedad, no una característica genética o histológica propia del paciente. Pese a todo, la AF sigue siendo muy útil en la evaluación de éstos pacientes.


































